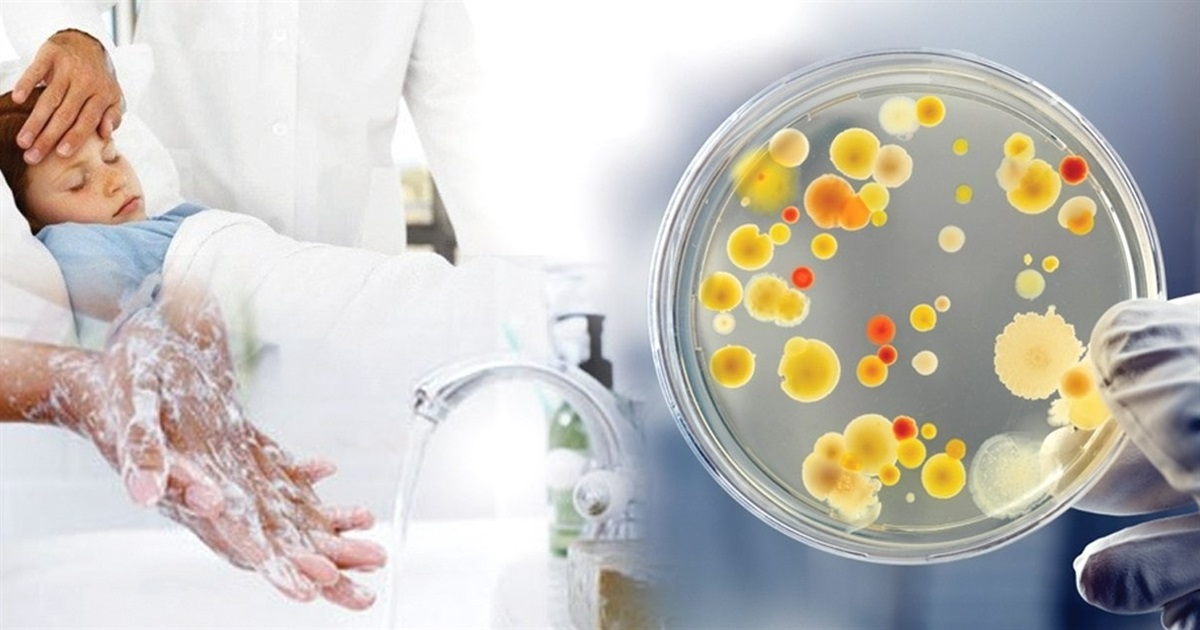

Про це під час брифінгу на офіційному медіа майданчику Сумської військової адміністрації повідомила заступник головного державного санітарного лікаря Сумщини Галина Зайцева.
За її словами, близько 100 тисяч людей звернулися до лікувальних закладів з інфекційними захворюваннями. Це майже на 20 % більше, ніж за аналогічний період минулого року, повідомляє Сумський обласний центр контролю та профілактики хвороб.
За 5 місяців 2024 року кількість людей ,які захворіли на інфекційні захворювання, за винятком респіраторних, становила майже 1200 людей. Із них хворих на гострі кишкові інфекції збільшилось на 15 % – 310 випадків.
- Так, інфекційні захворювання, в тому числі і сезонні, є явищем соціальним – на жаль, у реаліях сьогодення (військові дії, міграція людей, відключення електроенергії, перебої із водозабезпеченням) це відображається на рівні розповсюдження інфекційних захворювань. Невипадкового їх іще називають факторами війни, які можуть призвести до ускладнення та погіршення епідемічної ситуації і до поширення інфекційних хвороб, – зазначила Галина Зайцева.

У структурі зареєстрованих гострих кишкових інфекцій:
- гастроентероколіти встановленої етіології складали 135 випадків;
- гастроентероколіти невстановленої етіології – 121 випадок;
- сальмонельоз – 54 випадки;
- ротовірусний ентерит – 16 випадків.
За словами Галини Зайцевої, теж зросла захворюваність на ГКІ серед дітей – на 40%, порівняно з минулим аналогічним періодом.
Найчастіше збудники кишкових інфекцій знаходяться у сирій їжі тваринного походження (м’ясо, риба, яйця, молоко), немитих фруктах і овочах. Тому, Галина Зайцева особливо наголошує на дотриманні гігієни в побуті.
- Правила побуту дуже прості: зайшли до квартири – помили руки. Кухня і санвузол мають бути в ідеальній чистоті. Хочу нагадати два моменти, які на практиці мають велике значення: дотримання в холодильнику правила товарного сусідства. У кожної господині повинно бути щонайменше дві дошки для приготування: для сирих продуктів та для харчів, які одразу споживаються, - говорить заступниця.
Гострі кишкові інфекції – одні з найпоширеніших інфекційних захворювань, які можуть призвести до серйозних ускладнень, особливо у дітей. Спричиняються ГКІ бактеріями або вірусами.

Шляхи передачі:
- через уживання зараженої їжі та води;
- під час купання у забруднених водоймах;
- через брудні руки і предмети побуту.
Симптомами цих захворювань є:
- підвищення температури тіла;
- нудота;
- блювота;
- діарея.
Крім того, Галина Зайцева наголосила, що за наявності симптомів гострої кишкової інфекції необхідно обов’язково звернутися до лікаря.
Яка ситуація на Білопільщині
Як повідомили у Білопільській міській лікарні, з початку року зафіксовано всього три випадки на гострі кишкові інфекції. Щодо респіраторних інфекційних захворювань, зростання показників відбувається відповідно до сезону, починаючи з осені. Втім, інфекційне відділення працює у звичайному режимі, нестачі в лікарняних ліжках немає.